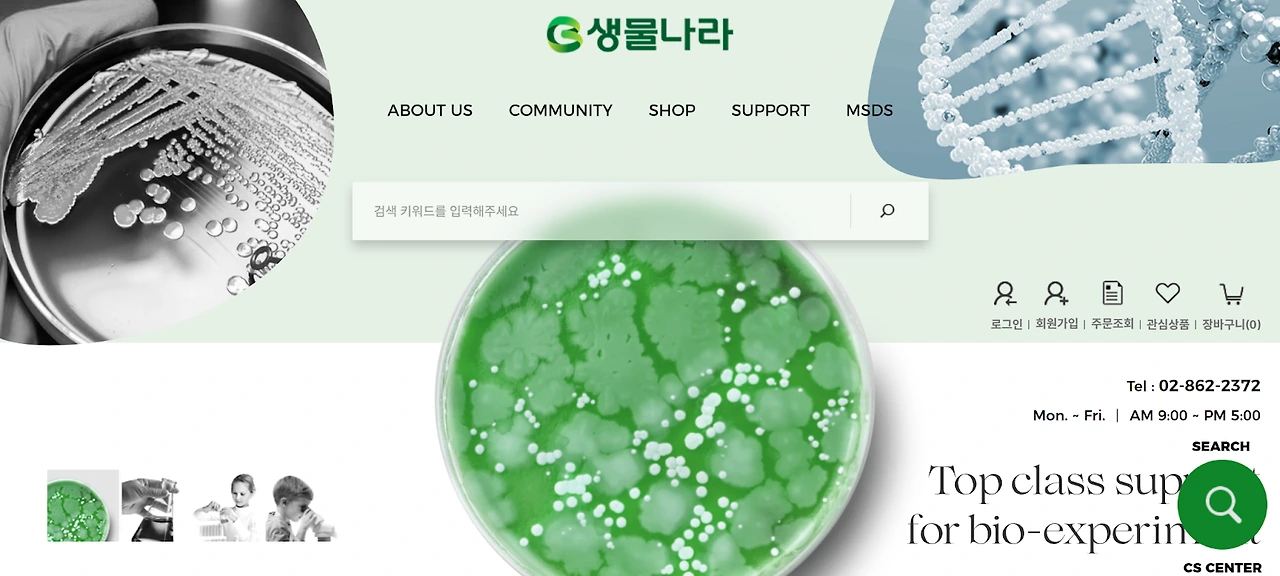
AD_4nXdwcfz9C94X2vYgzlIgZM5f8-r393e-LfoYZHpFfm_nk-EjQlQQZMyvhYVuk3EaJOZURW4-uZjXD_1ost4FZVVkxJwh6QnWN-uJCAj7DMdHg9DiiDHNnD0ZSN8x3lPEfvkC1ylS?key=pJ6u57G2cXVHgpegTW_z4_92

연세대 LSBT 생명과학공학 탐구 주제
+ 과학고 생기부 엿보기

안녕하세요 SRP 에듀입니다
연세대 LSBT 생명과학공학 전공을 목표로 하는 국내고, 해외고 학생들을 위해 심화 탐구 주제 찾는 법과 아주 유용한 웹사이트 목록을 가지고 왔습니다! 근데 이 내용 그냥 이과계열 학생들 모두에게 도움 정말 많이 될것 같아요 ☺️
1. 과학고 학생들의 생물, 화학, 물리, 지구과학 심화 탐구 보고서를 확인해 보자 �
서울특별시 교육청 융합과학교육원 웹사이트

https://ssei.sen.go.kr/fus/MI000000000000000074/board/BO00000126/ctgynone/list0010v.do
학생들을 대상으로 하는 과학 탐구 경진대회의 보고서를 모아 놓은 웹사이트 입니다
심지어 생물전공이 아니라 물리, 화학, 전기전자, 기계공학 등 다양한 이과 전공에 모두 쓰일 수 있는 탐구 보고서 내용입니다
고등학교 수준에서 최고로 잘 해낸 활동들이고 특히 과학고 학생들이 많이 수상을 했습니다
마치 이건 과학고 학생들의 생기부를 훔쳐볼 수 있는 느낌?! �
물론 여기에 있는 탐구 주제를 똑같이 따라하면 입시에 문제가 생기겠지만, 실험을 어떤 형태로 설계해야 하는지에 대한 도움은 무조건 받을 것입니다
해외고 학생들은 생물, 화학, 물리 EE, IA 주제를 찾는데도 엄청난 도움을 받을 수 있을거에요
또한 분야 (산업 및 에너지, 지구 및 환경, 생물, 물리, 화학 등) 별로 따로 수상을 하기 때문에 원하는 과목의 탐구 주제를 한눈에 보기에 쉽습니다
우선 흥미롭다고 생각되는 주제를 몇개 복붙해 왔습니다
회파블록의 방파면 각도에 따른 방파능력 탐구
탐구 동기: 테트라포드는 블록과 블록사이로 추락하는 안전사고나 해양쓰레기 문제가 심화되면서 문제점이 제기되고 있다. 이에 따라 대안으로 회파블록이 주목받고 있다.
기존 회파블록은 직립식으로 지반이 약한 곳에는 설치가 어렵다는 단점과 직립식 벽보다 경사식 방파제의 방파 효과가 더 높다는 연구 결과를 바탕으로 경사식 방파제에 회파블록을 융합시키는 방법을 고안하여 탐구를 진행하게 되었다.
탐구 방식: 기존 선행연구에서는 직벽, 테트라포드와 회파블록을 비교하였으며, 구멍의 개수, 크기, 탈출 각도를 변인으로 설정하였다. 본 연구에서는 경사식 방파제와 회파블록을 융합시켜 새로운 형태의 회파블록을 고안했으며 이에 따라 경사식 방파제의 장점을 직립식 방파제인 회파블록에 적용해 기존 경사식 방파제를 대체할 수 있을 것으로 보인다.
실험은 회파블록의 경사면 각도, 구멍의 갯수를 조정하여 반사파의 에너지를 측정하며 가장 높은 방파 성과를 낸 방파면 각도와 구멍의 갯수를 조사함.


 회파블록의 경사면 각도, 구멍의 갯수를 조정하여 반사파의 에너지 측정
회파블록의 경사면 각도, 구멍의 갯수를 조정하여 반사파의 에너지 측정세균의 PLA(친환경 생분해성 플라스틱) 분해능력 비교
탐구 동기: 친환경 플라스틱으로 PLA(Polylatic acid, 생분해성 플라스틱)를 인증하는 과정에서 미생물을 특정하지 않고 생분해도를 측정한다는 사실을 통해 어떤 미생물이 PLA(생분해성 플라스틱)를 분해하는 데 가장 효과적인지 알아보는 실험을 하게 되었다. 또한 EM(Effective Micro-organisms, 유용 미생물)과 같이 미생물을 사용하여 농업과 환경에 도움을 주는 것처럼 생분해성 플라스틱을 빠르게 분해하는 미생물 대량 배양이 플라스틱 쓰레기 문제에 해결책이 될 수 있을지 궁금하여 실험을 진행하였다.
지우개 성능 저하 현상에 대한 원인 규명 (이거 재미있어...! 독창적이야...!�)
탐구 동기: 지우개를 녹였다가 굳히면 지우개가 잘 지워지지 못하는 이유가 궁금하여 그 원인에 대해 탐구하였다. 지우개 성능 저하의 원인을 파악하고 그것이 해결 가능하다고 판단된다면 지우개에 흠집이 나도 녹여서 복구가 가능할 것이고, 나아가 예고나 미술학원에서 지우개의 재사용을 촉진할 수 있을 것이라 생각했다.
실험 방식: 지우개를 200°C에서 녹여 지우개 샘플을 확보하여 다양하게 분석하였다. FTIR 그래프의 C-Cl 결합 피크 크기를 표시하고 그 흡수율의 증감을 분석하고, SEM에서 지우개 표면을 촬영하고 imageJ 프로그램울 통해 thresholding와 masking 기능으로 다공성의 정도를 도출하였다. 지우개를 녹일 때 생기는 기체를 증류수에 통과시켜 pH 변화 여부를 보았다. 또한 샘플을 가지고 THF 용액을 6개 만들어 점도계 낙하시간을 구하고, 농도에 대한 환산점도 그래프를 Huggins equation를 따라 구한 절편값으로 Mark-Houwink Equation에 대입하고 분자량을 구하였다.
결과: 지우개를 녹일 때 지우개 고분자의 사슬 길이가 증가한다는 것이 성능 저하의 원인이라고 판단하였다. FITR C-C 흡수율이 약 5%p 증가하였고, 점도법으로 분자량이 약 3.4배 증가했음을 계산하였고, 용해도 이론을 이용한 정성적인 해석도 사슬 길이의 증가를 가르켰다.
빅카인즈 오늘의 이슈

뉴스를 통해서 탐구 동기나 주제를 찾을 수 있습니다. 빅카인즈에서는 한국의 뉴스를 전부 모아서 보여주며 ai검색을 통해서 내가 원하는 뉴스기사를 찾을 수 있습니다. 다른 ai검색과는 다르게 출처가 확인된 뉴스데이터 기반의 답변만 제공하기 때문에 검색이 편리하다는 장점이 있습니다.
다만 뉴스는 전문적인 내용이 없어서 보조도구로 활용하거나 주제의 아이디어를 얻을 때 사용하는 것을 추천할게요!
실험진행 시 도움이 되는 사이트
이과 학생들 실험 할 때 도움이 되는 사이트를 알려드리겠습니다.
보통 실험을 할 때에는 실험 재료가 필요한데, 일반적인 네이버쇼핑이나 쿠팡에서 구하기 힘든 재료들이 많아서 어려움을 많이 겪습니다. 그리고! 요즘은 생기부 기반 면접에서 학생이 직접 활동을 했는지 진위 여부를 따지기 위해 실험 재료를 어디서 샀는지까지 물어보신다고 합니다; 우리 잘 대비합시다!
- 디바이스마트

디바이스마트는 대부분의 전자제품과 기계부품들을 취급하기 때문에 공학계열의 탐구를 직접 수행할 때 필요한 모든 부품을 구매할 수 있는 아주 유용한 사이트입니다.
라즈베리파이, 아두이노 관련 물품을 구매할 수 있습니다.
- 생물나라

생물나라는 생명이나 화학 계열을 지원하는 학생들을 위한 시료나 실험키트를 구할 수 있는 유용한 사이트입니다.
해부용 뇌, 쥐, 돼지콩팥, 심장 표본 등을 팔고 있어요..
- 한국생물자원센터, 씨앗은행


생명과학 실험에 필요한 미생물이나 세포를 구매(분양)할 수 있는 사이트는 여기입니다!
대사물질, 오가노이드 세레우스균, 바실러스 서브틸리스 같은거 분양 받을 수 있음... ☺️
- 자주 나오는 지오지브라

https://www.geogebra.org/calculator
이건 문과 학생들도 쓰는 툴이고요!
고등학교 과정에서 배운 함수의 그래프를 수식만 입력하면 뿅 하고 그려줍니다
특히 그냥 수식을 설명했다 라고 끝나기 보다는 시각화, 그래프화 하였다가 훨씬 낫겠죠?
인문계 학생들도 더 더 많이 쓰길 바랍니다.
- 울프람알파

울프람알파는 수학 계산기의 고급 버전입니다. 울프람알파를 이용하면 미적분이나 벡터 계산과 같은 다양한 계산이 가능해요!
특히 미분방정식을 계산할 수 있는 것이 장점입니다. 미분방정식은 다양한 현상을 수식으로 직접 표현할 수 있지만 내용이 너무 어려워 고등학교 과정에서 사용하기는 어렵습니다 �. 하지만 변수분리형 미분방정식은 고등학교 과정으로도 이해할 수 있는 해법이고 이것만 알아도 다양한 상황을 정의할 수 있기 때문에 이과 학생들에게 추천합니다.
이외에도 실험결과를 정리할 때 엑셀이나 스프레드시트를 활용하는 것도 좋습니다.
그나저나 지우개 성증 저하 현상 실험한거 너무 창의적이고 재미있지 않나요?
가끔 저는 생기부 주제 떠올리면서 어 이 탐구 너무 재미있겠다! 라고 생각되는 것들이 있습니다
그리고 저랑 비슷하게 이 탐구를 하면 흥미롭겠다! 생각하는 학생들도 많더라고요, 그런 학생들을 만나면 정말 반갑습니다.
오늘도 능동적으로 생기부를 만드는 여러분이 되길 바라며,
SRP 에듀가 여러분을 응원합니다! �